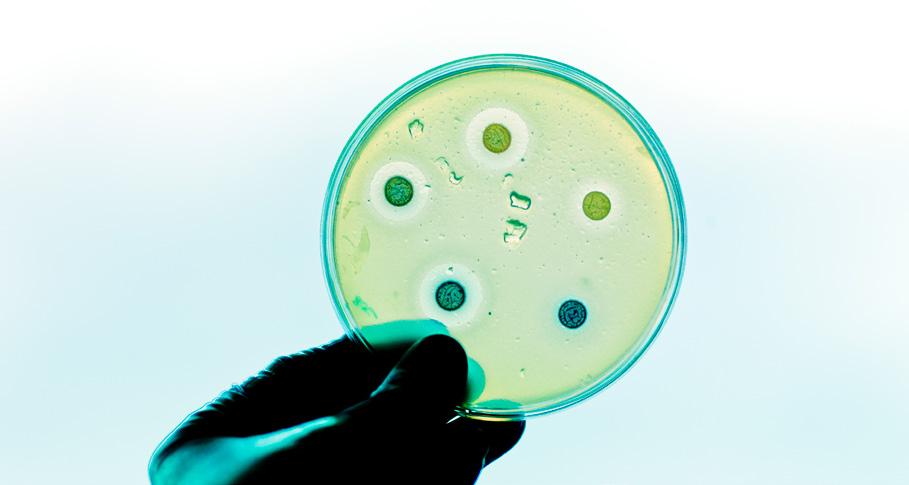

10 Workshops
430 Attendees 41 Countries
AUSTRALIA, BELGIUM, BRAZIL, BULGARIA, CANADA, CHINA, CZECH REPUBLIC, DENMARK, ETHIOPIA, FINLAND, FRANCE, GERMANY, GHANA, GRANADA, INDIA, INDONESIA, IRELAND, ISRAEL, ITALY, JORDAN, KOREA, LUXEMBOURG, MEXICO, MONTENEGRO, NETHERLANDS, NEW ZEALAND, NIGERIA, NORTHERN IRELAND, OMAN, PAKISTAN, PHILIPPINES, REPUBLIC OF KOREA, SAINT KITTS, SAUDI ARABIA, SOUTH AFRICA, SPAIN, SWITZERLAND, THAILAND, TURKEY, UNITED KINGDOM, UNITED STATES OF AMERICA
11 Fellows 14 Fellowship talks and events 11 Countries
15
JAPAN, ARGENTINA, SLOVENIA, NEW ZEALAND, AUSTRALIA, UK, INDIA, USA, ITALY, MALAYSIA, CHINA
Departments, Schools and Institutes across Surrey were involved in hosting Fellowships and workshops
Established in 2004, the Institute of Advanced Studies (IAS) at the University of Surrey sponsors workshops and Fellowships at the ‘cutting edge’ of science, engineering, social science and the humanities. Through this scheme the Institute fosters interdisciplinary collaborations and encourages a flow of international scholars, artists, entrepreneurs and public servants to visit, enjoy their stay at Surrey and leave behind excellent ideas and innovations. Over the years our events and Fellowships have resulted in many research grants, new collaborations, journal articles and books, as well as much goodwill from all over the world. The Institute is a member of the UK Consortium of Institutes of Advanced Study and the international Consortium of Humanities Centers and Institutes.
ias.surrey.ac.uk

INSTITUTE DIRECTOR
Professor Nigel Gilbert
Nigel Gilbert has a Distinguished Chair in Computational Social Science at the University of Surrey. He read for a first degree in Engineering and obtained his doctorate on the sociology of scientific knowledge from the University of Cambridge. His main research interests are processual theories of social phenomena, the development of computational sociology, and the methodology of computer simulation, especially agent-based modelling. As Director of the IAS, he is responsible for its development as a centre for international intellectual interchange.
n.gilbert@surrey.ac.uk

INSTITUTE COORDINATOR
Mirela Dumić
Mirela is responsible for the overall management of the Institute, including its annual grant competition and the Fellowship scheme. She supports the IAS Director in strategic activities and liaises with the Institute’s Advisory Board, the University’s academic community, external Fellows and similar institutes in the UK and abroad. She is also responsible for the Institute’s publicity and dissemination of outcomes from events and Fellowships.
m.dumic@surrey.ac.uk

INSTITUTE ADMINISTRATOR
Louise Jones
Louise provides general administrative support to the Institute with a particular focus on the workshops that run each year following the Annual Competition. She is the main point of contact for workshop organisers and their administrators. In addition to her role for the Institute of Advanced Studies, Louise is the Administrator and Assistant to the Head of Sociology.
l.jones@surrey.ac.uk

“
Established in 2004, the Institute of Advanced Studies (IAS) at the University of Surrey sponsors workshops and Fellowships at the ‘cutting edge’ of science, engineering, social science and the humanities.
This year’s Annual Review celebrates 20 years of the IAS: two decades of discussion, collaboration, research and innovation. In this publication, in addition to showcasing the highlights of this year’s IAS workshops and Fellowships, we take a look back at the evolution of the Institute and some of its key milestones.
The seed of inspiration for the IAS was sown by an event I organised in the Department of Sociology: in 1991 twenty four people from around the world gathered at Surrey for a workshop on ‘social simulation’. This instigated a new field of research and it occurred to me how beneficial it would be for the University if more workshops of this type could be funded. Some years later, in 2004, the IAS was born. We invited academics to bid for funding, and a panel made up of Distinguished Professors judged each year’s applications.
The IAS was set up to fund workshops across all disciplines, and later extended its remit to include funding for Fellowships. We welcomed our first Fellows in 2017 and this has grown steadily over the years, with 11 Fellows visiting Surrey in 2024. We are part of a network of similar institutes across the world, and proud members of the UK Consortium of Institutes of Advanced Study and the international Consortium of Humanities Centers and Institutes.
Since its formation the IAS has achieved much, and you can read about some of our most notable successes on pages 20-21. A workshop that particularly stands out for me was one led by Professor Jim Al-Khalili and Professor Johnjoe McFadden on quantum biology in 2012. This event helped to kickstart what has become a very important area of research at Surrey.
Coming full circle, in 2024 artist-in-residence Alex May has collaborated with the Arrow of Time project research team and created a spectacular digital artwork which portrays different aspects of quantum biology. You can read about his Fellowship on page 22.
I would like to take this opportunity to thank Mirela Dumić, who has been the Institute’s Co-ordinator since 2007, for her incredible contribution. Without her enthusiasm, hard work and innovative mind, the IAS would not have taken the shape, or enjoyed the great success, that it has.
The IAS was set up to bring a new dimension to Surrey’s research activities, attracting a flow of international scholars to the University, and encouraging new, productive research collaborations. Looking at the events and Fellowships we highlight in this Annual Review – from a workshop on traditional phonograph recording using wax cylinders to a Fellow from Slovenia whose driving simulator could help keep people and the roads safer – it is clear that the IAS has remained true to that vision. We are proud of everything the Institute has achieved so far, and look forward to the next chapter of collaboration and research.
Professor Nigel Gilbert IAS Director

“
Since its formation the IAS has achieved much, and you can read about some of our most notable successes on pages 20-21. We are proud of everything the Institute has achieved so far, and look forward to the next chapter of collaboration and research.
Professor Nigel Gilbert
The IAS Advisory Board’s members are senior members of the University faculty, including the Associate Deans of Research and Innovation from the three Faculties, and an external member. The Institute’s Advisory Board advises on the strategy of the Institute and reviews and recommends which bids should be funded in the annual competition

RACHEL BROOKS
Professor of Sociology and Associate Dean, Research and Innovation Faculty of Arts and Social Sciences

MARIALAURA DI DOMENICO
Professor of Entrepreneurship, Work and Organization

DAN HORTON
Reader In Veterinary Virology and Associate Dean, Research and Innovation Faculty of Health and Medical Sciences


MARK CHAMBERS
Professor of Microbiology and Disease Intervention

DERK-JAN DIJK
Professor of Sleep and Physiology

JOSEF KITTLER
Professor of Machine Intelligence
MARGARET RAYMAN
Professor of Nutritional Medicine

GREVILLE CORBETT
Professor of Linguistics

NIGEL GILBERT
Professor of Sociology

JUSTIN READ
Professor of Astrophysics

JIN XUAN
Professor of Ceramic Materials and Associate Dean, Research and Innovation Faculty of Engineering and Physical Sciences

PROFESSOR RAO BHAMIDIMARRI
Chairman, Carbondown
12-13 June 2024
Taking a fascinating glimpse into the past, an IAS workshop gave participants the opportunity to experience a traditional phonograph recording session in action, and investigate how folk songs were recorded before the 1930s.
As Director of Surrey’s Early Recording Association, and one of 40 ‘Surrey Future Fellows’ highlighted as leaders in their fields, Dr Inja Stanović has hosted workshops exploring traditional recording techniques on many occasions. However until now, she has never focused her attention on the non-classical music of the time.
“When I spotted the IAS funding call for workshops I realised this could be a wonderful opportunity to explore how nonclassical genres such as folk music were recorded prior to the availability of electrical recording equipment,” says Inja.
“Wax cylinder phonographs work without an electric signal. You wind up the machine, put in a ‘wax blank’ and sing or play into the horn – and you can listen back to the recording immediately.”
Invented in the 1890s, wax cylinder phonographs were light and easy to transport, which made them the ideal way of recording folk music among local communities all over the world.
The two-day workshop brought together a “wonderful mishmash” of around 30 academics, expert musicologists and musicians, researchers, and representatives from institutions such as the British Library, National Museum in Prague, the BBC and the City of London Phonograph and Gramophone Society (the oldest society of its kind in the world).
On the first day, two keynote talks provided an enlightening introduction to the practical workshop section of the event.
Dr João Silva (Institute of Ethnomusicology, NOVA University, Portugal) discussed the role played by recorded sound in ethnology, anthropology and musicology during the early phonographic era, and how the ability to study human diversity through sound waves became a staple of an age shaped by nationalism and colonialism. Will Prentice (Austrian Academy of Sciences) discussed exactly what we hear when we listen to ethnographic cylinder recordings.
In the mechanical phonograph workshop, led by Duncan Miller (founder of the Vulcan Cylinder Record Company), participants were treated to a range of performances in musical traditions from around the world including sevdah music by renowned Bosnian singer Damir Imamović. Each performance was designed to answer a specific research question – such
as the problems of recording piano during Dr Eva Moreda Rodriguez’s sung performance, accompanied on piano by Inja. Despite being played loudly, the piano sounded surprisingly soft on this recording.
Dr Aleksander Javier Kolkowski played James Scott Skinner’s ‘The Weeping Birches of Kilmorack’ on both the violin and the Stroh violin – a trumpet-shaped instrument which is very rarely performed, but recorded extremely well. Another highlight was the session by Ziazan, a singer and instrumentalist trained in the tradition of the ancient Italian singing school, bel canto. During her performance Ziazan invited the whole audience to act as her choir during ‘The Herring’s Head’, learning the chorus as they went along – which reflected how songs were taught

It has been a unique opportunity to experience the recording process of a wide range of performers with individual music styles and learn from the observations they offered of their process. This conference has weaved together the practical and theoretical strands of early recordings, by way of traditional music on wax cylinders, and in doing so has nurtured an exciting dialogue that I look forward to continuing soon.
Dr Fatima Volkoviskii
Watch the presentations

Inventedinthe1890s,wax cylinder phonographs were lightandeasytotransport , whichmadethemthe ideal way of recording folkmusicamong local communities all over the world .

With global warming having a daily and devastating impact on communities around the world, scientists of all disciplines are focused on accelerating the development of more sustainable technologies and approaches. This year IAS sponsored five workshops which furthered our race towards Net Zero.
/ 24 June 2024
ORGANISED BY
Dr Hui Luo (School of Mechanical Engineering Sciences; Institute for Sustainability)
THE CHALLENGE
The use of electrochemical conversion to turn biomass from agriculture, plastics and industry waste into energy and chemical production – providing an alternative to fossil fuels – is currently limited by the lack of efficient and stable catalyst materials and the feasibility of scaling up.
THE HIGHLIGHTS
Held in collaboration with the University Global Partnership Network, and aligned with UKRI’s vision for a greener future 11 talks revealed cutting-edge discoveries in areas such as green hydrogen production and utilisation; biomass valorisation; and CO2 capture, storage and utilisation
Speakers included:
Professor Geramo Tremiliosi-Filho (University of Sao Paulo): overview of the hydrogen market in Brazil
Dr Bahman Horri (Surrey): introducing SurreyH2, a recently patented hybrid water-splitting process
Professor Magda Titirici (Imperial College London): producing carbon materials using biomass hydrothermal carbonisation
Dr Santosh Kumar (Diamond Light Source): understanding the electronic and geometric structure of electrocatalysts using powerful X-ray techniques.

WHO ATTENDED?
15 academics and researchers working at the cutting-edge of research into electrochemical energy conversion from world-leading universities and research centres.
WHAT NEXT?
Researchers from Surrey, Technical University of Denmark and Diamond Light Source are joining forces for collaborative projects that combine experimental studies with theoretical modelling
Organiser Dr Luo is planning publication of her research on plastic electrolysis, with a larger grant proposal due to build on her collaboration with University of Sao Paulo.
WHAT DELEGATES SAID
“I learnt many new techniques that are very beneficial for my PhD study. I will for sure explore chances to use them.”
“It was lovely meeting many old and new faces, and forming new collaborations. Thank you for the invitation and wonderful hospitality.”

AI and sustainability: our people-centred approach
16 May 2024
ORGANISED BY
Dr Arshdeep Singh (Centre for Vision, Speech and Signal Processing)
Despite AI being a widely used technology, large-scale AI models are not energy efficient and may generate high levels of CO2. How can we develop and deploy AI sustainably, and what tools can we use to measure its impact on the environment?
Expert leadership and input from Surrey’s Institute for Sustainability and Institute for People-Centred AI
Eight talks by international and national speakers from industry, academia and research institutes including Microsoft AI for Good Lab, NVIDIA Corporation Singapore, The Alan Turing Institute, and the Universities of Oxford, Lorraine (France) and Christian Medical College in Vellore (India)
Talking points included:
GridCarbon: a project which tracks the changing carbon intensity of the UK electricity grid
Improving the sustainability of climate and weather predictions using AI
Computational and hardware efficiency using neuromorphic computing.
44 in-person and 23 online attendees including computer scientists, social scientists, and law and regulation experts from universities across the world.
Online presentations are being made available to share insights with a wider audience
Potential new research collaborations around responsible AI, decarbonizing AI models and improving public awareness.
A post-event survey with participants found that:
71% thought the format was ‘definitely useful’ for understanding AI and sustainability
64% had improved their understanding of AI and sustainability
93% had gained what they were expecting from the event
93% would be likely or extremely likely to recommend a similar event to colleagues.
“It opened up new horizons for AI integration into my start-up, Greenbrigade Private Limited in Punjab, India.”
“ The workshop demonstrated the need for more communication between disciplines – including law and regulation.
Sustainability, imagination and aesthetics
26-27 June 2024

BY
Dr Carl Thompson and Dr Anastasia Loukianov (Surrey Institute for Sustainability)
How can aesthetics and the creative arts contribute to creating inspiring, positive visions for a sustainable future – rather than apocalyptic depictions – in order to win the hearts and minds of the public?
Hybrid event led by the newly formed Sustainability, Creativity and Communication (SusCC) group within Surrey’s Institute for Sustainability
19 presentations by 21 speakers across 7 sessions focused on core themes such as ‘placemaking’ (the relationship between local communities and their environment), and education and policy
Key talking points:
What influences our aesthetic tastes and how are these changing as we embrace sustainability?
The tendency to create architectural design that only appears ecologically responsible is problematic and wastes resources
How teaching environmentally-focused art practices can help students move beyond climate ‘overwhelm’ to positivity and a sense of agency
The emergent genre of ‘solarpunk’ which aims to inspire people with positive visions
The importance of storytelling in connecting people and communities to their localities
Showcase sessions presenting H and T Creative’s dance performance No Time to Waste; Alex Holland’s online magazine SolarPunk Stories; and the role of artwork in Extinction Rebellion’s work by activist Trish Kiy.
WHO ATTENDED?
Academics, arts practitioners and activists from the UK, Germany, Luxembourg, Finland, New Zealand, Australia and Canada.

WHAT NEXT?
Publication of a special issue of papers in a relevant publication such as Contemporary Aesthetics
Potential for future collaborations and joint funding bids via connections built between academics, arts practitioners and environmental activists.
“ Art and the imagination can be vital springboards to helping us visualise (and so eventually achieve) alternative, better futures. Dr Carl Thompson

Delegates heard presentations from 21 speakers from across academia, the arts and activism.
19-21 June 2024
ORGANISED BY
Dr Wooli Bae (School of Mathematics and Physics)
Synthetic biology enables new ways of making fuel, food and fabrics with a low carbon footprint, but to realise its full potential we need to develop better ways to predict performance.
Themed days on synthetic biology (experimental and theoretical) and single-molecule biophysics
Presentations from academics leading research globally on topics including:
–
Metabolic engineering of yeasts to produce vitamins, nucleosides and lipids
– Identifying chemical agents for clearing entire organisms
– Deep learning models for synthetic biology systems
– DNA repair machinery using single-molecule fluorescence.
Demonstration of state-of-the-art microfluidic system
Lunchtime poster session for 15 PhD and postdoctoral researchers to showcase their research projects
Special event for early career researchers including university tour
Sponsorship by the British Embassy Seoul, Biotechnology and Biological Science Research Council, National Research Foundation of Korea, and Korea Advanced Institute of Science and Technology.
ATTENDED?
Academics from leading universities in Korea, Japan and the UK.
Second workshop on the same theme planned in Korea in March 2025 to further build a collaborative network.
The event was well organised on a beautiful campus in Guildford.
Professor Won-Ki Cho
I am happy with the amount of discussion and interaction I had during the poster session.
Dr Javier Cabello Garcia
The venue was so nice and I liked the fact that everything occurred on one site for focused discussions.
Professor Inwha Baek

Digitally-enabled circular economy
2 May 2024
Dr Lei Xing (School of Chemistry and Chemical Engineering; Surrey’s Institute for Sustainability and Institute for People-Centred AI)
Digital technologies such as ‘digital twins’ (which simulate real world industrial scenarios) accelerate manufacturing processes. How can they best be used to help the UK transition to Net Zero?
Expert input from sponsors CircularChem Centre and OXCCU, as well as the Alan Turing Institute, Global Centre of Excellence in Sustainability, Siemens, Yokogawa, Nottingham Trent University, Heriot-Watt University, Cranfield University, Imperial College London and University of Leeds
Keynote speakers covered topics such as the philosophical foundations of digital twins, how simulations are being used to evaluate the circular supply chain for medical devices, and the latest advances in the field
A panel discussion brought unique perspectives on issues such as boosting industrial competitiveness and advancing scientific inquiry
Ideation workshop brought the focus to key questions such as how the Internet of Things and cybersecurity can be implemented to support the circular economy.

Participants were divided into three groups to discuss key topics, each led by an expert in that area.
Academics, researchers, industrial companies and sustainability experts.
Collaborative bids for recent EPSRC funding calls including ‘Sustainable Industrial Futures’ and ‘Manufacturing Research Hubs for a Sustainable Future’
Professor Benoit Chachuat (Imperial College London) to collaborate with Dr Lei Xing on a joint publication, providing co-supervision for a Surrey PhD student.


Two of our workshops focused on very different aspects of health but both have the potential to make a difference to people’s lives – whether through better education of healthcare professionals or more collaborative approaches to the control and elimination of tropical diseases.
Integrative interventions across neglected tropical diseases to support sustainable public health policy
9-10 May 2024 Health workshops
Dr Joaquin Prada (School of Veterinary Medicine)
Neglected Tropical Diseases (NTDs) have a large burden of chronic illness and mortality, impacting over 1 billion people worldwide – including some of the world’s most vulnerable, marginalised populations. Control and elimination programmes usually target a specific disease in isolation, but to meet ambitious goals set by the World Health Organization for 2030, we need collaborative, integrated approaches.
High level speakers from important bodies such as the World Health Organization, World Organisation for Animal Health, and US Center for Disease Control and Prevention
Focus on ‘One Health’ approach, with the inclusion of speakers on animal health and zoonotic viral diseases
Presentations from different perspectives such as Professor Guy Howard (University of Bristol) on water, sanitation and hygiene as the ‘forgotten key’ to tackling NTDs
Practical breakout sessions which identified the key criteria and requirements for an integrated programme
Identification of the most important criteria for shared learnings across different NTDs, eg having a common transmission pathway or the chance to improve efficiency in both diseases.
ATTENDED?
20 delegates in person and almost 100 online, from undergraduates to PhD students, early career researchers and established academics.
“ “ “
My favourite part of the event was the brainstorming sessions on what are the parameters we should look at to get programmes working, and how we can find ways to collaborate across sectors – not just focused within NTDs but also looking at other health promotion or disease control programmes for completely different types of pathogens.

For me, the biggest take home has been around how much people really value integrative approaches.
My takeaway from the workshops was about people. Amazing to hear different people’s experiences of NTDs but also working together, collaborative approaches and different people’s experiences of it across the world. The expertise that we have in the room has been amazing.

Identification of educational milestones and Entrustable Professional Activities for Day One prescribing competence
14 May 2024
ORGANISED BY WHO ATTENDED?
Dr Martin Hawes (School of Veterinary Medicine)


41 educators from 11 countries, from the fields of veterinary medicine, medicine, pharmacy and nursing.
THE CHALLENGE WHAT NEXT?
Medication errors are a leading cause of avoidable harm in patients. How can we build on existing competency-based education to improve ‘Day One prescribing competence’ (the minimum standard required for new graduates).
THE HIGHLIGHTS
Practical small group task-oriented sessions to identify and then sequence sub competencies for safe and effective prescribing
Chance to learn about the Competency-Based Veterinary Education (CBVE) framework which was used as an exemplar tool during the workshop
Knowledge sharing by delegates with different levels of experience.
An initiative to review and update Day One pharmacology competencies (previously published by Werners and Fajt in 2021)
Mapping these competencies to the CBVE framework
Developing a tool to support curricular design and guide student assessment.
WHAT DELEGATES SAID
“ “
I now have a much better understanding of the principles of curriculum design and development – it is all so much more logical than I thought.
I see that there is an issue in how we teach. We focus on the stuff (content) and then expect learners to make connections between knowledge. I guess it comes down to the old question of whether we are teaching them to know science or the art of practice.

Following the workshop, in June 2024 the Journal of Veterinary Pharmacology and Therapeutics published the paper ‘Is it time to stop teaching pharmacology and focus on treatment planning instead?’, while a second paper will shortly appear in the Journal of Veterinary Medical Education.



An IAS workshop on young people’s experiences of online harms has resulted in the publication of a book of edited papers, Children, Young People and Online Harms, published in February 2024. We caught up with workshop organiser and author of the book Dr Emily Setty (Sociology).


What’s been the response to the new book?
It’s been positive! The Online Safety Act has just come into law, and our promotion of the book on social media has attracted engagement from academic and policy/practice audiences about the implications of the Act. I’m actively involved with a High Level Working Group for Privacy and Safety with Meta/Instagram on this and I’m incorporating key arguments and themes from the book about children’s rights and an ecological framework to addressing online harms into this group.
We’ve also seen the book referenced by the Australian Medical Association in its submission to a Parliamentary Inquiry into influence and impacts of social media on Australian society.
How has this book changed the conversation about online harms for young people?
The book argues that adult engagements with young people can be counter-productive. We have evidence-based insights about the ways adults may overstate or misconstrue online harms, disembedding them from the wider contexts of young people’s lives

and, in turn, losing credibility with young people. It’s not about downplaying harm but about avoiding just imposing an adult perspective.
Are there further plans to disseminate this research?
Yes, we’re now planning a global edition of the book which will be made up of chapters by contributors from a diverse range of countries. The first book mainly focuses on the UK context, but we know that the issues are global and various jurisdictions are dealing with online harms, including with new forms of legislation. There’s a need for nuanced appreciation of how the issues unfold for young people in diverse cultural contexts.
“We’ve also seen the book referenced by the Australian Medical Association in its submission to a Parliamentary Inquiry into influence and impacts of social media on Australian society.
Dr Emily Setty

Coming from the human-vision field, for me the workshop provided a great opportunity to learn about the latest developments in machine learning and deep neural networks for action recognition. There were really good interactions between researchers from both human and computer vision, and this was particularly helpful for the early career attendees.
Quoc Vuong (Newcastle University)
15 May 2024
What if computers could not only recognise objects but also understand activities from video in a similar way to humans? An IAS workshop, focused at the nexus of computer science and psychology, advanced understanding on this most crucial of questions.
In the unstoppable march of AI, there is a problem: the need for explainability. If a computer has the power to decide whether we are right for a job or eligible for a loan based on unseen data and algorithms, there is a danger that the conclusions it comes to are not fair or – importantly – not explainable.
“As computer scientists we might be able to learn some new tricks by studying how humans perceive things, and use these to create better AI systems,” says Dr Frank Guerin of Surrey’s School of Computer Science and Electronic Engineering.
“CCTV cameras are common but, as yet, computers don’t have the human perception skills needed to monitor these. For example you might ask a computer to tell you if it sees someone stealing a handbag in a restaurant, but the computer tends to get confused by superficially similar actions. It might see a man appearing to take a woman’s handbag when in reality the man is picking up his wife’s bag, and she is fully aware of the situation.”


With this challenge in mind, Frank organised a workshop which brought together academics and researchers in computer science, psychology and neuroscience from universities across the UK – as well as Surrey’s Institute for People-Centred AI.
Two keynote speakers, both well-known figures in their fields, gave interesting insights into the challenges and solutions of the future. Computer scientist and Royal Academy of Engineering Fellow Professor Sean Gong (Queen Mary University of London) talked about next generation vision language models which will gather data from millions of captioned videos on the internet.
The limitation with these, he said, will be that the quality of captioned videos available is not always good, and much useful video is also restricted by GDPR and therefore not available for training AI – two challenges which future AI systems will need to work around.
Keynote speaker Professor Frank Pollick of the University of Glasgow’s School of Psychology and Neuroscience explored how we perceive things visually. His research strips a human image down to tiny ‘motion cues’ – points such as elbows – and looks at what information the brain needs to understand how people are moving (for example dancing), whether they are male or female, and even how happy they are.
Delegates got to hear from a range of viewpoints including PhD student Toby Perrot (University of Bristol). His talk ‘Out of sight not out of mind’ revealed how head cameras can be used to gain a full 3D map of an area such as a kitchen, enabling a computer to understand why people are doing certain things – an approach which could enable elderly people to live independently.
Neuroscientist Dr Nicholas Hedger (University of Reading) delivered a talk by video link which demonstrated how our brains and bodies react as a result of what we see. Playing scenes from popular movies, he showed how watching these stimulates different parts of our brains, which causes us to feel bodily sensations that reflect what we’re watching.
An extended lunchtime session gave delegates plenty of time to chat, while the poster session facilitated some interesting discussions. A particular benefit of this was that early career researchers got the chance to talk directly to well-known figures in the field.
Frank hopes that the workshop sets in motion future research. There are already plans for a multidisciplinary project looking at recognising the emotional content in video, and taking advantage of computer science techniques to run psychology experiments. One example is the use of ‘inpainting’: a technique where parts of a video are obscured to identify which are the critical features a human needs in order to understand what is happening.
Frank says: “In AI, pure deep learning approaches are prevalent but there are obvious problems with these when it comes to explainability. It was great to have the opportunity to put computer vision and human perception experts in the same room to talk about how these could be combined to create systems that behave more like humans.”
The past 20 years have seen many highlights for the IAS: workshops and Fellowships that have brought real change and moved the conversation. Here we bring you just a few examples.
External academics / Artists-in-residence Entrepreneurs / Public Servants
Almost 5,000 participants from all over the world
Our Microbial Systems Biology workshop in 2005 was a major milestone in Surrey’s pioneering research and leadership in this field, resulting in grants totalling £1.3 million.
The workshop provided new ideas that helped us to initiate several new projects which have been successful in generating both publications and new grants in microbial systems biology.
Professor Johnjoe McFadden
As the climate crisis worsens, IAS workshops have increasingly addressed sustainability themes. The first, in 2008, focused on improving green practices in universities and attracted almost 200 delegates. This year has seen five sustainability workshops on a varied range of topics – from ‘digital twins’ in manufacturing to the way the arts can create a positive vision of the future. (Read about these workshops on pages 10-14.)


In 2009, the event ‘From Animals to Humans: A Multidisciplinary Approach to the Study of Zoonotic Diseases’ was a vital step in forging a new global partnership between Surrey and North Carolina State University.

A workshop on canonical typology in 2009, organised by Surrey Morphology Group, led to the publication of a landmark book on the topic. Canonical Morphology & Syntax was the first book to present canonical typology as a framework for comparing constructions and categories across languages.
2011 was the 100th anniversary of Gustav Mahler’s death and our conference in that year, dedicated to the composer, is still spoken about as one of the most memorable events in the Mahler pantheon. Bringing together experts from all over the world, it led to the publication of Rethinking Mahler by Oxford University Press in 2017.
Our workshop on quantum biology in 2012 kickstarted a major new field of research at Surrey and led to the publication of Life on the Edge: The Coming of Age of Quantum Biology in 2014.

By inviting all the principal research players in the field to the IAS workshop we gained access to the latest data in the field and became known as ‘players’ in quantum biology. This recognition was likely a factor in the eventual success of our grant proposal to the Leverhulme Trust to establish a Quantum Biology Doctoral Training Centre at Surrey.
Professors Johnjoe McFadden and Jim Al-Khalili
A review paper on anion-exchange membrane electrochemical systems –published in 2014 as a result of an IAS workshop the previous year – provided an important resource for those working in the field and has now gained over 2,000 citations.
Surrey is a leader in research into sleep and circadian rhythms, and this is reflected in seven IAS workshops dedicated to sleep over the years – culminating in our 2023 event which marked 20 years of multidisciplinary research at the University.
Visiting Surrey in 2017, IAS Fellow Associate Professor Kristen Knutson (Northwestern University, USA) conducted research which established that ‘night owls’ have a 10% higher risk of dying sooner than ‘morning people’. This groundbreaking work made national media headlines in the UK and US.
Since welcoming UK bio-artist Anna Dumitriu and J R Yancher of California’s Bike City Theatre Company in 2021, our Artist-in-Residence scheme has gone from strength to strength. Three Artists-in-Residence are due to visit Surrey in 2024-25 to collaborate with Surrey’s academics in music, psychology and biosciences.
The impact of the scheme is far-reaching: artworks created at Surrey by Anna Dumitriu have been displayed in exhibitions at the Nobel Prize Museum in Stockholm and the V&A Museum in London.

I would like to congratulate the Institute of Advanced Studies on the immense contribution it has made to advancing knowledge and fostering collaborations within Surrey, the UK and around the world over the last 20 years.
Since its establishment, the IAS has been a pioneer of interdisciplinary collaboration – an ethos which today is more important than ever as we address the global challenges of our time.
At Surrey, we are proud of the IAS’s successes and impact. As we celebrate this milestone, I am confident that the Institute will continue to make a positive difference to peoples’ lives and to transform societies globally.
Professor Max Lu President and Vice-Chancellor


One of the distinguishing features of the IAS is to provide a forum for different fields of endeavour, aiming to identify and discuss the current research challenges, with a view to defining future research directions. This is very different from conventional workshops and conferences, set up primarily to disseminate and discuss recent research outputs.
Professor Josef Kittler (Founding member)

The IAS has been a valuable means for excellent research to be recognised and supported, outside the standard administrative structures. In particular, newer researchers have been fostered.
Professor Greville Corbett (Founding member)
Surrey host: Dr Youngchan Kim, School of Biosciences
Communicating concepts of quantum biology in a visually-exciting way was a huge but ultimately satisfying challenge for artist-in-residence Alex May.
Combining a range of sciences from quantum physics to chemistry to biology, quantum biology is a highly complex intersection of traditional disciplines – but one that could hold the foundational answer to how living organisms function. It explores how quantum effects (where particles can be in different places at once, or travel through seemingly impenetrable barriers) influence the natural world, which may explain processes such as DNA mutation.
Alex May, a digital artist specialising in memory, identity and technology, set himself the task of communicating elements of quantum biology through a video sculpture based around the concept of a ‘Cabinet of Intangible Curiosities’. In July 2024, this artwork was unveiled both to experts in quantum biology at a specialist workshop, and to staff and students from across the University at an ‘In Conversation’ event on campus.
Alex’s creative process began with conversations held during many visits to Surrey with his Fellowship host Dr Youngchan Kim (School of Biosciences), Director of the Quantum Biology Doctoral Training Centre, and colleagues involved in the interdisciplinary ‘Quantum Arrow of Time’ project.
Due to the abstract nature of quantum mechanics, there was little for a visual artist to ‘see’ in the lab, which added to the challenge of getting under the skin of the subject, but talking to academics working at the cutting edge of the science proved fascinating for Alex.
“It gave me a window into the wide-ranging and varied work that goes into science that outsiders don’t get to see,” he says. “For me, quantum biology has parallels with the idea of memory. Two people can experience the same event and have a shared memory that could be considered ‘entangled’, in a purely metaphorical sense of course.”
The concept of a ‘cabinet of curiosities’ is reminiscent of explorers who would bring home specimens from far-flung lands, such as the skulls, teeth and bones of exotic animals.
Alex explains: “I thought this was an interesting metaphor for quantum biology where we cannot see the actual quantum effect that exists in this other distant land. Instead we are looking for its result – an artefact of its existence, like a shadow of something you can’t look at directly.”

“ Obviously Alex had to simplify some of the concepts of quantum biology to create something meaningful but my colleagues loved it. One element showed a cloud passing through a building which they thought was a brilliant concept to explain quantum tunnelling.
Dr Youngchan Kim

The ‘cabinet’ presents digital cameos showing different examples of quantum effects, such as the European robin which possesses the remarkable ability to navigate using a unique interaction between a light-sensitive protein present in its eye and the earth’s magnetic field. Other visual symbols include a clock where the second hand keeps jumping back to reflect the reversibility of time, and a mummified cat spirit to demonstrate the Schrödinger’s Cat paradox.
The artwork received a positive response from both academics and lay people. On 5 July around 40 academics from Surrey and other institutions attended a blue sky thinking workshop organised by the ‘Quantum Arrow of Time’ project team where Alex presented his project for the first time.
Youngchan says: “Obviously Alex had to simplify some of the concepts of quantum biology to create something meaningful but my colleagues loved it. One element showed a cloud passing through a building which they thought was a brilliant concept to explain quantum tunnelling.”
The exhibition had a similarly warm reception at an ‘In Conversation’ event on 11 July, when Surrey students and staff from across the faculties were given the chance to view the exhibit and listen to an explanation from Alex and Youngchan.
Alex says: “People seemed really excited about the artwork. While I hope they went away having learned something, my goal wasn’t just knowledge transfer: I wanted to bring people closer to a seemingly illogical subject on an intuitive level, so I was really happy with their reaction.”
Youngchan adds: “We academics tend to find it difficult to explain our research in simple language. The journey with Alex has given me the chance to broaden the way I talk about my work.”
Physicist Professor Jim Al-Khalili, who has led Surrey’s work in quantum biology, said: “This field is complex and highly interdisciplinary as it requires insights from many areas of science, so for an artist to be able to gain a broad picture of the field was hugely challenging. Yet Alex somehow managed to achieve that. His beautiful ‘cabinet of curiosities’ installation brought together the science in an evocative and profound way that I believe helps scientists view what they do with fresh eyes.”
“This field is complex and highly interdisciplinary as it requires insights from many areas of science, so for an artist to be able to gain a broad picture of the field was hugely challenging.
Professor Jim Al-Khalili


Professor Jian Xu, Nanjing Institute of Environmental Sciences, China
Surrey host: Dr Benyi Cao, School of Sustainability, Civil and Environmental Engineering
A 2024 Fellowship has already reaped rewards, with the publication of research outlining an innovative approach for reducing pollution caused by pesticide production.
Soil and groundwater contamination by organic pollutants from chemical plants presents significant risks to both environmental and human health – and this is a particular problem in many developing countries.
Visiting Surrey in August 2023, Dr Jian Xu collaborated with his host Dr Benyi Cao to research a solution to this challenge. For the first time, they combined in-situ chemical oxidation technology with groundwater circulation well

The Fellowship focused on researching ways of reducing pollution caused by pesticide production.
(GCW) technology in order to improve the speed at which pollutants degrade.
The collaboration achieved the first commercial deployment of a GCW-based low disturbance remediation strategy, and the research demonstrated that the levels of contamination in soil and groundwater were significantly reduced.
Jian and Benyi’s research was published in Science of the Total Environment in September 2024.

Dr Rohan Shah, KEM Hospital Research Centre, India

Rohan Shah
Surrey hosts: Dr Agnieszka Lemanska and Dr Anand Ahankari, School of Health Sciences
Understanding more about the complex causes of anaemia – which affects over 50 per cent of adolescent girls and women in India – was the objective of Dr Shah’s Fellowship at Surrey.
Anaemia in childhood and adolescence affects physical and cognitive development, and in females it can impact pregnancy and newborn health, with India experiencing the largest anaemia burden globally. While iron deficiency is the most common cause, the fact that anaemia persists despite iron-folic acid supplementation programmes suggests that other factors may increase the risk.
Dr Shah’s Fellowship continued an ongoing collaboration with Dr Anand Ahankari and Dr Agnieszka Lemanska to address the lack of research on anaemia in rural India, using data collected in the Maharashtra Anaemia Study Phase 2 (MAS 2). The team has succeeded in identifying critical demographic, social and nutritional factors contributing to anaemia in rural adolescent girls – findings which are soon due to be published in an academic journal.
Visiting the University of Surrey from May to July 2024, Rohan formed links with leading institutes including the Usher Institute at the University of Edinburgh and Surrey’s Global Centre for Clean Air Research. He delivered a lecture to masters students at Manchester Metropolitan University and presented his research at the Maternal Child Cluster meeting at Surrey. Demonstrated by the widespread interest it has attracted, this research has not only succeeded in advancing understanding of anaemia in adolescent girls, but has also emphasised the need for nuanced and tailored interventions in public health.
Rohan says: “The Fellowship has allowed me to experience and contribute to a new work culture in a beautiful country with kind people. I am deeply grateful to the IAS for this exceptional opportunity.”
Anand adds: “The IAS Fellowship provides a wonderful opportunity to engage international researchers to advance projects to improve health and wellbeing.”
“ The IAS Fellowship provides a wonderful opportunity to engage international researchers to advance projects to improve health and wellbeing.
Dr Anand Ahankari



Workshop on process simulation for undergraduate students of chemical engineering.
Having created open-source software in collaboration with his host Dr Michael Short to help developing countries transition to renewable energy, Dr Dominic Foo visited Surrey to take this technology to the next stage, and promote the concept to UK industry.
One of the main purposes of Dr Foo’s Fellowship was to improve the original software through further research funding. During his first visit to Surrey in October 2023, he worked on a grant application with Dr Short which led to the team being awarded a Research and Innovation for Development in ASEAN grant of £60,000 for a six-month project to develop policymaking tools for energy system decarbonisation.
This research project has now started, with an Energy and Climate Workshop – held at Surrey during Dominic’s second visit in July 2024 – providing a valuable opportunity to exchange ideas on setting energy and emission targets, as well as carbon prices. The workshop gathered researchers from Surrey and other institutions, along with participants from the UK government’s Foreign, Commonwealth and Development Office, and global engineering company Pace CCS.
During the Fellowship Dominic and Michael also organised a hands-on workshop on process simulation for undergraduates, and a talk for postgraduate students and academic staff on the lifecycle of journal publication – both of which were very well-received by their audiences.
Psychology
A visit by Entrepreneur Fellow Dr Atsushi Maki of Hitachi Ltd has started a dialogue with Surrey academics which could pave the way for life-enhancing technologies in areas such as ageing, healthcare and sleep science.

Advanced AI-based technologies have the potential to nurture minds and bodies through the design of toys which improve cognitive development, for example, or tools to encourage better verbal interaction.
Dr Maki visited Surrey in May 2024 with the aim of exploring how learnings from psychology and cognitive science can inform the devices and systems that support people to live healthier lives in the future.
As well as giving talks to present his company’s work in AI, robotics and near-infrared spectroscopy, Atushi engaged with research groups and centres across the University to talk about opportunities for collaboration. This included visiting Surrey Sleep Research Centre to discuss the relationship between dementia and sleep with Professor Derk-Jan Dijk, and meeting academics on a tour of the Surrey Institute for People-Centred AI to talk about language information processing. A chat with Professor David Frohlich, Director of the Digital World Research Centre, explored whether ‘consolidating’ memories using images, audio and video could protect memories in people with early dementia.
Following Atushi’s visit, a number of research collaborations between Surrey and Hitachi Ltd are now on the horizon, as well as possible exchange visits and internships with Keio University and Chuo University in Japan.
“
Dr Maki visited Surrey in May 2024 with the aim of exploring how learnings from psychology and cognitive science can inform the devices and systems that support people to live healthier lives in the future.
Surrey host: Professor Robert Meadows, Department of Sociology
The topic of sleep is often in the media, and the importance of sleep for healthy ageing is increasingly recognised, but the social and cultural perspectives reflected in this content are often narrow.
Dr Gibson’s Fellowship was focused on developing and launching a collaborative study which explores the representation of sleep and ageing in the British tabloid and broadsheet press. Added to her work on sleep and ageing in the New Zealand media, these findings will inform understanding of discussion on sleep and help to provide more realistic and empowering messages around sleep, health and ageing in the future. She also presented a fascinating seminar on navigating cross-cultural research – along with Surrey anthropologist Dr Jonathan Skinner – which included case studies from her collaborative works concerning sleep experiences of older Māori and non-Māori people.
While at Surrey, Rosemary and her host Professor Meadows held a one-day workshop which brought together academics from sociology, psychology and the Surrey Sleep Research Centre, and welcomed external contributors. Three propositions
were identified as key for future work in this space: ontological and epistemological questions; issues of agency, autonomy, habits and routines; and issues relating to time and temporality. Outputs from the workshop included commissioned art works to illustrate these dominant themes.
Future research could more closely consider the rhythms of aged care and temporality of medication use, as well as the rhythms of sleep as indicators of ageing, disease, and stigma.
Rosemary says:
“ In New Zealand, sleep has seldom been considered as a social science so the IAS Fellowship provided me with a fantastic opportunity to network with international leaders in the sociology of sleep and ageing.

Surrey host: Dr Robert Izzard, School of Mathematics and Physics
Combining two simulation codes could enable astrophysicists to uncover secrets about how and why stars explode. Thanks to Dr Melina Bersten’s Fellowship at Surrey, this coupled code will soon be available as open source.
When a star explodes, it tells a story. A supernova – the death of a star – coincides with a huge release of energy, and this can provide vital information about chemical elements in our universe. Astrophysicists use simulations to explore the build-up of energy inside stars, examining how different factors, such as the size of the star and whether it is a single or binary star, affect the process.
“The only way we can understand the production of most elements here on earth is because we know they must be produced in a star: there is no other explanation for chemical elements than a supernova explosion,” explains Dr Bersten of the Instituto de Astrofisica de La Plata in Argentina.
Melina’s Fellowship and visit to Surrey’s School of Mathematics and Physics in June 2024 was part of a long-term collaboration
with Dr Robert Izzard, whose research focuses on binary stars (where a star interacts with a companion). Having originally met in Mongolia in 2014 at a conference focused on binary stars, the pair became interested in exploring how binaries, and a star’s interaction with its companion star, could affect the way they explode.
The objective of the IAS Fellowship was to produce a simulation code which couples Melina’s ‘simple and fast’ code for observing supernova ‘light curves’ (the intensity over time) with Robert’s large-scale population synthesis research. They will compare the observable features of supernovas from these simulations with the results of large surveys enabled by advanced instruments such as the Large Synoptic Survey Telescope.
The initial code has been formulated and successfully tested, and Melina and Robert are now working on producing a final version of the coupled code which they will publish in open source format.


“Melina’s visit introduced us to invaluable new code, enhanced our skill set, and provided fresh direction for our research. The integration of supernovae, particularly supernova light curves, into our models represents an exciting opportunity for both astrophysics and nuclear physics at Surrey. This aligns very well with our faculty’s mission to bridge diverse fields of study, significantly advancing our future research potential.
Dr Robert Izzard

Astrophysicist
Dr Noelia Noël (right) was one of the academics Melina connected with during her visit.
This code could hold the key to a lot of information. Melina says:
“At the extreme end, it could tell us about the possible effect an exploding star could have on Earth. The Betelgeuse star, for example, is expected to explode ‘soon’ (in astrophysics terms). Using our simulation it will be possible to determine whether this has the potential to destroy life.
“Learning more about supernovas also helps us to measure distance. They are extremely bright and if we know their intrinsic energy we can tell how far away they are, so we can use them to understand the size of the universe.”
During her visit to Surrey, Melina gave a colloquium about supernova light curves, telling the story of Argentinian amateur astronomer Victor Buso who, in 2016, accidentally photographed a supernova at the earliest stage ever seen, and became the first person in the world to witness the wave of energy just before a star explodes.
Melina’s visit to campus was only two weeks (with much of the Fellowship research happening remotely) but while at Surrey she connected with academics and researchers, particularly in nuclear physics, with a view to future collaborations.
“The in-person visit gave me the opportunity to get to know the University, and I really appreciated the chance to have discussions with Robert’s students.
“I come from Buenos Aires which was obviously a big contrast with Guildford and its beautiful surrounding area. Seeing the sunset while walking in the Surrey Hills was a highlight for me,” she says.
“I also learned some new ways of working. In Robert’s group they use a lot of channels on Slack (the business messaging app) which are a great way of starting discussions on new opportunities like research papers, and I’ve started to use these channels now in my own group. Another positive thing at Surrey is the culture of suggesting a quick coffee and chat with colleagues. Our type of research means we’re mainly working on a computer but we’re social creatures – and when you get together and talk, the ideas start to appear.”
Robert comments: “Melina’s visit introduced us to invaluable new code, enhanced our skill set, and provided fresh direction for our research. The integration of supernovae, particularly supernova light curves, into our models represents an exciting opportunity for both astrophysics and nuclear physics at Surrey. This aligns very well with our faculty’s mission to bridge diverse fields of study, significantly advancing our future research potential.”
Surrey host: Professor Nishanth Sastry, School of Computer Science and Electronic Engineering
Professor Black and Professor Sastry have – for the first time – been able to study how thousands of satellites can link to enable internet access in Antarctica.
Space networks based on mega-constellations (thousands of small low earth orbit satellites) have the potential to provide high speed internet access to people living in the most remote regions on Earth. However more understanding is needed about what affects the connectivity and resilience of these systems.
Having previously partnered to build SpaceNet – the first space network which emulates the changing connectivity provided by mega-constellations – Jonathan’s IAS Fellowship enabled him to collaborate further with Nishanth to improve the facility.
Leveraging a US National Science Foundation funded project, Jonathan and Nishanth and their teams have deployed a Low Earth Orbit (LEO) node to Antarctica, and studied the inter-satellite links which enable internet access in this remote location. The Fellowship has enabled them to carry out resilience and connectivity tests, with joint experiments between Surrey and Virginia Tech. They have also developed the groundwork for
examining how mega-constellations might behave in the face of disruptions such as large solar storms or jamming by hostile states. Publications, presentations and recordings related to the project are publicly available on space-net.org.
As part of the Fellowship Jonathan and Nishanth organised a workshop in June which brought together the transatlantic team and interested observers to demonstrate deploying and interconnecting network emulators.
Following on from the Fellowship, Jonathan and Nishanth are planning future collaborations including a SpaceNet workshop in September and LEO-Net workshop at Mobicom in November 2024, as well as working with the NASA Artemis program.
Jonathan says:
The Fellowship’s foundational support was crucial to building this sustained collaboration.

Having previously partnered to build SpaceNet – the first space network which emulates the changing connectivity provided by mega-constellations – Jonathan’s IAS Fellowship enabled him to collaborate further with Nishanth to improve the facility.
Dr Matteo Pellegrini, Università Cattolica del Sacro Cuore, Italy
Surrey host: Professor Erich Round, School of Literature and Languages
How did Latin evolve into today’s modern Romance languages? Dr Matteo Pellegrini visited Surrey’s School of Language and Literature to develop a computer model to provide some answers.

Over and above this planned research, Matteo has contributed to the Surrey Morphology Group’s internal skill sharing programme, and his state-of-the-art datasets for Latin and Italian have been released as Open Data.
The Fellowship enabled Dr Pellegrini and Professor Round, with the collaboration of Dr Sacha Beniamine, to scale up previous simulation models with much larger datasets. Focusing on Italian, they have used the new model to observe ‘analogical’ changes in verbs (when a formal pattern in one word is transferred to another similar word) and found more stability than was previously observed in the way verb forms tend to evolve.
These research results are soon to be presented at the Surrey Linguistic Circle while, in the longer term, there are plans to publish them.
Over and above this planned research, Matteo has contributed to the Surrey Morphology Group’s internal skill sharing programme, and his state-of-the-art datasets for Latin and Italian have been released as Open Data. An abstract on this topic, submitted by Matteo and his Surrey colleagues, has recently been announced winner of the University’s ‘Open Research Award’ event.
Surrey host: Dr Karen Gravett, Surrey Institute of Education
Online learning necessitated by the Covid pandemic affected marginalised students’ sense of belonging.
Dr Sarah O’Shea’s Fellowship shone a light on this enduring problem.
Visiting the University in June 2024, Dr O’Shea immersed herself in Surrey’s research community, working with academics across sociology and education, and learning about their current work in areas such as student engagement, relational pedagogies, spatial injustice, youth uses of social media, and gender equality.
A key focus of the Fellowship was the launch of a new website, belongingtouniversity.co.uk, which showcases Sarah and Dr Gravett’s research and was launched at a presentation on ‘The Politics of Student Belonging’ on 11 June. The website gives users access to a series of downloadable images which bring to life how students feel about the idea of belonging and are designed to prompt discussion.
Sarah also made two thought-provoking presentations to researchers at Surrey which encouraged them to consider their own direction and how theory from other geographies –such as Australian higher education – could be used across their own work.
She says:
“
My Fellowship visit allowed my host and me to work intensively together and definitely improved the quality of a bid we have submitted for work which builds on student belonging.

Surrey host: Dr Nikolas Thomopoulos, Surrey Hospitality and Tourism Management
With no universal assessment tool available, how can doctors tell whether elderly people are safe to continue to drive? Professor Jaka Sodnik’s Fellowship presented a solution and put it to the test.
Having designed the SimFit2Drive driving simulator at the University of Ljubljana in Slovenia, Professor Sodnik and his Surrey host Dr Nikolas Thomopoulos (Associate Professor in Transport) applied for an IAS Fellowship in order to test the concept with UK drivers and move towards commercialisation.
“
The Fellowship experience was great and ran very smoothly. We’re already planning my next visit to Surrey and I’m hoping Nikolas will be able to visit me in Slovenia too to discuss joint grant proposals.
Professor Jaka Sodnik
In May 2024, a group of volunteers with no health-based license restrictions aged between 18 and 92 were invited onto campus to take part in driving scenarios on the simulator, which had been transported from Slovenia to Surrey and was located in Surrey Hospitality & Tourism Management. This testing represented the first time an IAS Fellowship has engaged with the local community to conduct research.
Jaka, an electrical engineer specialising in information and communication technologies and human machine interaction, explains: “As we get older there is a decline in our vision, reaction times, motor and cognitive skills and, for some people, this decline reduces their ability to drive safely.
“If you look at a graph of driving accidents, there’s a U-shaped curve with the youngest and oldest drivers involved in the most casualties per mile.

SimFit2Drive could help doctors to determine whether elderly people are safe to continue to drive.
But whereas young people undergo a driving test, older drivers do not.”
The successful testing of SimFit2Drive provided vital baseline data that will enable the system to identify when a driver’s results fall outside the expected parameters. The test also enabled Jaka and Nikolas to acquire valuable information from UK drivers as volunteers were asked to give feedback on their experience, answering questions such as ‘Does the simulator closely resemble real-world driving?’ and ‘Would you be happy to use the simulator as part of a holistic driving test?’
The simulator features large screens which simulate different kinds of driving conditions, and tests both participants’ physical agility (for example steering the wheel and applying the brake) and cognitive skills, as they are required to follow the speed limit and change lanes based on instructions given in advance.
“Participants across all ages appreciated the simulator,” says Nikolas. “That included older people who got their licence 60 years ago and younger, recently-qualified people who said that they would have welcomed training on this type of simulator to build their driving confidence.”
A key objective of the Fellowship was to network and gauge the support of UK driving organisations and other stakeholders. Jaka and Nikolas held a series of workshops where they demonstrated the simulator, inviting representatives from Driving Mobility, DVLA, the NHS, Surrey and Hampshire County Councils, rehabilitation centres and safe driving groups.
“We aimed to get the most relevant audience in the room and we definitely achieved that,” says Nikolas, who visited the Queen Elizabeth Foundation – part of the Driving Mobility network – with Jaka at the beginning of the Fellowship.

Having used earlier generations of driving simulators, Driving Mobility is currently exploring available options to renew its stock of simulators in selected parts of the UK. Jaka’s IAS Fellowship and workshops held at Surrey have contributed to SimFit2Drive featuring as a leading solution.
Vicki Parker (an occupational therapist and Driving Mobility trustee) comments: “Driving Mobility centres have been using simulators to assess able and disabled drivers for a number of years. We are always excited to see how new technology can continue to support people in maintaining their independence and accessibility levels, so this is a promising option.”
Jaka says: “In addition we’re talking to Hobbs Rehabilitation Centre about using the simulator with its patients. This could obviously be a really useful tool for assessing when someone who has had a stroke is fit to drive again.”
The plan is for the simulator to remain at the University until June 2025 while Jaka and Nikolas continue their collaborative work with local and national stakeholders. Their joint efforts have
already resulted in them being invited to join a European network of experts focused on this challenge.
With the European Commission actively looking for a solution which unifies driving assessment for elderly people, the time seems right for this technology. “In our ageing society we believe this system could improve driving safety on a European or even an international level, as well as providing vital support for health experts and older people’s families,” says Jaka.
“Jaka has brought a fresh perspective and enabled us to focus on an area that has been underresearched in the past. We’ve found that there’s not only local but also national interest in the simulator and there are potential links with tourism too. We think it could have real impact in the future.
Dr Nikolas Thomopoulos
In 2022-23, Surrey’s Global Centre for Clean Air Research (GCARE) welcomed two IAS Fellows –Dr Anwar Ali Khan, a public servant working for the Delhi Pollution Control Committee, and urban heat expert Associate Professor Sebastian Pfautsch of Western Sydney University, Australia.
Since his Fellowship, Anwar has co-authored a review with Professor Prashant Kumar (Director of GCARE) in Science Direct (March 2024) which demonstrates that India’s megacities need to work with neighbouring rural areas to tackle air pollution. He has been made Member Secretary of the State Level Environment Expert Committee and is playing a key role in advocating for improved air quality by publishing research, developing guidelines and policy, and speaking at high profile conferences.
Meanwhile Sebastian has co-authored a publication on ‘Climate change: strategies for mitigation and adaptation’ in The Innovation Geoscience, and is leading a new AU$3.34m project on managing resilient green spaces in Australian cities. He was also promoted to Professor following his Fellowship at Surrey.
Professor Kumar says:
“ I am grateful to the IAS for the opportunity to host two distinguished experts from India and Australia. The IAS Fellowship platform has fostered long-term collaborations, continuing to generate impactful outcomes in air quality and urban overheating challenges.


Dr Anwar Ali Khan Professor Sebastian Pfautsch
After her Fellowship at Surrey exploring how the timing of food relates to increased risk of obesity and metabolic disorders, Professor Cibele Crispim’s research has moved on apace. She has co-authored an article with her Surrey host Professor Debra Skene, which was published by the European Journal of Nutrition in March 2024, and been invited to write a book chapter on sleep and obesity for the Brazillian Sleep Association.

Continuing her partnership with Surrey – this time focusing on the relationship between chrononutrition and ultraprocessed foods – Cibele has renewed her Productivity Research Grant funded by Brazil’s National Council for Scientific and Technological Development for a further three years. She has also organised an international online course for the Graduate Program in Health Sciences at the Federal University of Uberlândia, which will feature five renowned speakers including Dr Cheryl Isherwood from Surrey.

Professor Sebastian Schlecht, whose IAS Fellowship explored how mathematical tools can be used to help create perceptually convincing audio experiences, presented a joint paper at the 27th International Conference of Digital Audio Effects, held at Surrey in September 2024. He has also recently been promoted to Associate Professor for Signal Processing at the Friedrich-Alexander-Universität Erlangen-Nürnberg, Germany.
Having visited Surrey in spring 2023 to research the part played by Eastern philosophy in Victorian culture with host Professor Patricia Pulham, Dr Oindrila Ghosh has signed a contract with Oxford Bibliographies to write an essay on the social reformer Edward Carpenter, who features prominently in her research project.
As a result of her research she also presented an invited paper at an international conference hosted by the Indian Institute of Advanced Study on the ‘Rise of Vegetarian Societies and Vegetarianism in Late-Nineteenth Century’ in November 2023. Oindrila has also been appointed to the editorial board of the Victoriographies journal following her Fellowship.
Oindrila says:
“
The Fellowship has been extremely beneficial and has enriched my CV.

Dr Hannah Mary Thomas visited Surrey in 2023, hosted by Professor Philip Evans, to research new techniques for diagnosing head and neck cancer using AI-based medical imaging.
Since then, Hannah has continued to make strides as the Research Lead at the Quantitative Imaging Research and Artificial Intelligence Lab, which she co-founded at her institution, the Christian Medical College in Vellore, and is the first centre of its kind in India. She has also secured funding from the Bill and Melinda Gates Foundation to study the perception of AI among healthcare professionals in India, and completed two training fellowships at Maastricht University.

Hannah has maintained strong links with Surrey and was invited to make presentations at both a British Nuclear Medicine Society meeting in Harrogate and the IAS workshop on people-centred AI in 2024 (see page 11 for our report). The next stage of her long-term collaboration with the University will be a visit to Vellore by PhD student Will Tapper from the Centre for Vision, Speech and Signal Processing.
“The IAS Fellowship keeps on giving,” says Hannah.
“Our collaborative research gave us new insights and led to a publication but, just as importantly, it resulted in valuable connections that continue to impact my career.





DR MAE CARROLL
University of Melbourne, Australia
Surrey host: Dr Sacha Beniamine, Surrey Morphology Group Fellowship focus: Investigating a system to help understand and classify ‘inflectional morphology’ (the way words are formed in certain grammatical categories).
PROFESSOR GUILHERME ROSA
University of Wisconsin-Madison, USA
Surrey host: Dr Christos Dadousis, School of Health Sciences Fellowship focus: Furthering and promoting the use of AI, big data and informatics to improve animal health and livestock production.
DR PRANAV KHANDELWAL
Virginia Polytechnic Institute and State University, USA
Surrey host: Dr Robert Siddall, School of Mechanical Engineering Sciences Fellowship focus: Developing animal-inspired gliding robots to monitor the ecosystem.
PROFESSSOR PATRICK MIKALEF
Norwegian University of Science and Technology, Norway
Surrey host: Dr Athina Ioannou, Business Analytics and Operations Fellowship focus: Exploring the strategic and business value of Generative AI technologies and how they affect people’s trust in organisations.
PROFESSOR ANASTASIYA LIPNEVICH
City University of New York, USA
Surrey host: Professor Naomi Winstone, Surrey Institute of Education Fellowship focus: Translating research on the impact of feedback in education into practice, and establishing an international Feedback Lab.


ASSOCIATE PROFESSOR BINGFENG ZHANG
China University of Petroleum (East China), China
Surrey host: Professor Wenwu Wang, Centre for Vision, Speech and Signal Processing (CVSSP)
Fellowship focus: Solving a fundamental problem in computer vision by developing a method for segmenting objects found in images in real-world scenarios.
ASSOCIATE PROFESSOR TIRTHA BANERJEE
University of California, Irvine, USA
Surrey host: Dr Giovanni Iacobello, School of Mechanical Engineering Sciences
Fellowship focus: Combining multidisciplinary knowledge on wind flows over forested hills with advanced data analysis to improve weather and climate environmental modelling.



HARRY YEFF
Independent artist, UK
Surrey host: Dr Enzo De Sena, Institute of Sound Recording, Department of Music and Media
Fellowship focus: Producing voice-centred experiences at the cutting-edge of spatial audio technology.
SIMON RAVEN
Independent artist, UK
Surrey host: Professor Victoria Tischler, School of Psychology
Fellowship focus: Exploring the psychology of ableism by developing a satirical series of ‘unproductive’ participatory and therapeutic art activities.
BORIS ALLENOU
Independent artist, UK
Surrey host: Dr Marine Petit, School of Biosciences
Fellowship focus: Developing a creative piece of music representing the unseen consequences of global warming on the UK tick species Ixodes Ricinus.

DR GUOSHENG HU
Oosto, UK
Surrey host: Professor Ioana Boureanu, School of Computer Science and Electronic Engineering
Fellowship focus: Exploring responsible face analysis techniques and how this concept is applied in the real world.
BOARD 2024-25
We are delighted to announce our Advisory Board for 2024-25, and particularly to welcome two Surrey Future Fellows who have been highlighted under this new scheme as leaders in their field.

EMILY CORRIGAN-KAVANAGH
Surrey Future Fellow

DEBORAH DUNN-WALTERS
Professor of Immunology (Associate Dean Research and Innovation, Faculty of Health and Medical Sciences)

CATHERINE MCNAMARA
Head of Guildford School of Acting (GSA)

JUSTIN READ
Professor of Astrophysics

DERK-JAN DIJK
Professor of Sleep and Physiology

NIGEL GILBERT
Professor of Sociology (IAS Director)

JANE OGDEN
Professor of Health Psychology

EMMA TAYLOR
Surrey Future Fellow

MARIALAURA DI DOMENICO
Professor of Entrepreneurship, Work and Organization

JOSEF KITTLER
Professor of Machine Intelligence

GLENN PARRY
Professor of Digital Transformation (Associate Dean Research and Innovation, Faculty of Arts, Business and Social Sciences)

JIN XUAN
Professor of Sustainable Processes (Associate Dean, Research and Innovation, Faculty of Engineering and Physical Sciences)

PROFESSOR RAO BHAMIDIMARRI
Chairman, Carbondown
